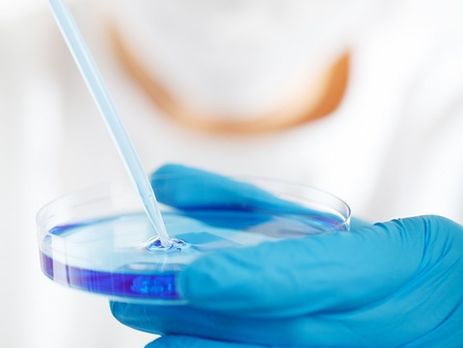
Корь в Одесской области. Количество заболевших возросло до 75

корь

Вспышка кори в Одесской области: число заболевших детей увеличилось до 58
10:35, 22 января 2019

С начала года корью в Украине заболели более 5 тыс. человек – Минздрав
16:03, 15 января 2019

С начала 2018 года корью в Украине заболело более 52 тыс. человек – Минздрав
21:40, 26 декабря 2018